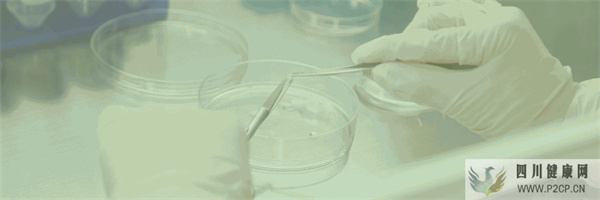
首创牙髓再生术,创造了乳牙干细胞的新里程碑(图1) 首创牙髓再生术,创造了乳牙干细胞的新里程碑(图1)
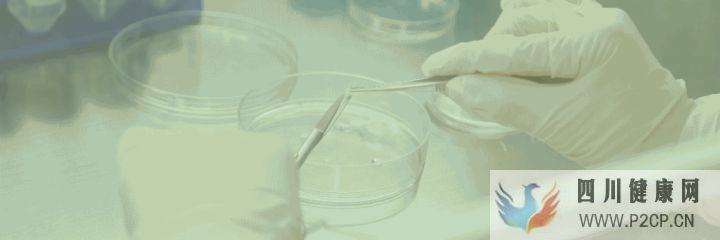
首创牙髓再生术,创造了乳牙干细胞的新里程碑(图2) 首创牙髓再生术,创造了乳牙干细胞的新里程碑(图2)

首创牙髓再生术,创造了乳牙干细胞的新里程碑

壁虎尾巴断了能重生,鲨鱼牙齿掉了会长起来,为什么人类一生只有乳牙和恒牙,牙齿掉了不能再生?这一奥秘一直困扰着世界各国科研人员。8月29日,空军军医大学口腔医院召开国际首创牙髓再生术新闻发布会,空军军医大学口腔医院组织工程中心金岩教授经过20年不懈努力,成功实现了牙髓再生,这一技术将弥补目前根管治疗技术的诸多不足,使得口腔疾病治疗迈入新的发展阶段。


发布会当天上午,空军军医大学口腔医院的医生为一名8岁的小女孩实施了牙髓再生术,并通过网络在发布会现场进行了同步手术直播。


这名小患者3个月前受伤,最近父母发现孩子的上前牙牙龈脓包5日余,曾在其他医院治疗,但效果不理想,11牙(已经长出的恒牙)牙髓发生坏死,后来到空军军医大学口腔医院就诊。医生通过综合评估之后,决定为其实施牙髓再生术。医生将小患者即将脱落的乳牙拔出,对乳牙中的牙髓干细胞进行提取,在实验室进行干细胞聚合体培养,培养成功之后,再将培养好的牙髓神经体移植到这名小患者恒牙的根部,帮助患者恢复牙髓,达到牙齿再生的目的。


口腔疾病中,牙病发生率占人体各器官疾病之首,特别是龋病、牙髓病发生率高,是人类最普遍的疾病之一,其主要原因是龋病引起的牙髓炎症或牙髓坏死导致的牙“死亡”,世界卫生组织已将其与肿瘤和心血管疾病并列为人类三大重点防治疾病。200多年来,牙髓病在临床治疗中均采用“根管治疗”术,就是口腔医生通过人工操作,分次彻底清除牙齿髓腔与根管中的牙髓细胞,并用生物材料进行填充。由于没有营养供给,充填后牙齿虽然得以保留,但会逐渐变得脆裂和变色,同时也丧失了感觉,特别是咬硬物的时候容易折断。好比一棵没有营养供给的枯树,时间久了变得干裂,遇到大风容易折断。因此,实现牙髓再生一直是一项世界难题。


多年来,空军军医大学口腔医院金岩教授率领的科研团队,在成功研发出具有自主知识产权的中国第一个组织工程“人造皮肤”和世界第一个生物眼角膜后,通过模拟牙发育原理,建立基于干细胞自组装的细胞聚合体技术,利用脱落乳牙干细胞成功实现了全牙髓组织的功能性再生,开展国际首个全长牙髓再生的临床研究并获得成功。具体讲,就是从患者脱落乳牙中获取牙髓干细胞,经过一个月左右体外培养,将形成的干细胞聚合体植入患者所需的牙髓腔里,使得牙齿神经血管再生,完全恢复牙齿原有功能。特别是对于牙齿正在发育的年轻患者,能使牙齿发育到正常状态。


目前,该技术已用于临床近50例患者,均已完全成功。其成果以该院金岩教授为通讯作者、美国宾夕法尼亚大学施松涛教授为共同通讯作者,该院儿童口腔科轩昆教授和口腔病理科李蓓副教授为共同第一作者,发表于国际学术界具有极高影响力的美国《科学转化医学》权威期刊上,引起国际同行广泛关注,影响因子达16.71,这也是该杂志创刊以来第一篇口腔临床转化研究领域文章。


该技术的成功研发,改变了人类200多年来传统的牙病治疗理念,特别是为下一步牙齿再生领域的研究,具有重要的里程碑式意义。临床推广应用后,也必将再次为广大牙病患者带来福音。
文章来源于网络,如有侵权请联系






